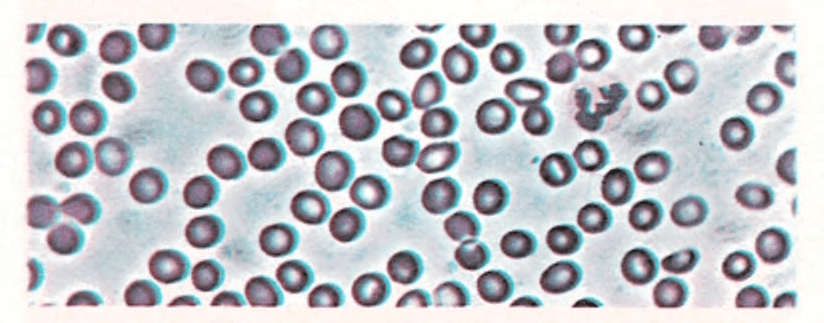

Queloide
Es el crecimiento inofensivo y progresivo del tejido que cubre una cicatriz producida por cortes, quemaduras, punciones o incisiones. Los queloides aparecen más a menudo entre los individuos de raza negra que entre los caucasianos. Los médicos no saben exactamente las causas que originan el queloide.

Durante los primeros meses los queloides son rosados o rojos; luego pierden el color. Producen picor con frecuencia y a veces son blandos, sobre todo cuando se hallan en contacto con la ropa. Pueden disminuirse al máximo las molestias e incomodidades, ateniéndose a las siguientes normas:
■ Vestir al niño con ropas amplias de seda y nylon, evitando el algodón y la lana.
■ Procurar que el niño no pase calor.
■ Darle diariamente masajes suaves con lanolina.
Existe la posibilidad de que el médico recomiende un tratamiento de rayos X o la inyección de un preparado especial de cortisona, que tal vez reducirá el tamaño y las molestias del queloide.
En ocasiones, el médico puede extirpar un queloide muy molesto. Desgraciadamente tienden a reproducirse, aun después de haber sido extirpados.
Quemaduras
Oscilan desde las molestias insignificantes hasta las lesiones graves que

pueden causar mutilaciones e incluso la muerte. Las quemaduras se clasifican en tres grados según su gravedad.

El primer grado es cuando sólo se produce enrojecimiento de la piel, pero no llega a formarse ampolla. En el segundo grado, la quemadura produce enrojecimiento de la piel y ampollas. En el tercer grado se destruyen la piel y los tejidos, pudiendo penetrar más profundamente en el organismo y causar lesiones graves.

se pone al niño inmediatamente
debajo de agua corriente, como por ejemplo
la ducha, mientras se le quitan las ropas.
Las pequeñas quemaduras de primer grado, generalmente no son graves y requieren un tratamiento mínimo. Para disminuir el dolor, basta simplemente con poner la zona quemada bajo agua fría durante unos minutos o aplicar una bolsa de hielo. Si el dolor persiste se puede poner un poco de gelatina de petróleo y cubrirlo con una gasa. No se utilizará margarina, mantequilla u otro material grasiento.
En las quemaduras de segundo grado de pequeña extensión, se seguirá el mismo procedimiento anterior, pero se consultará al médico ante toda quemadura de segundo grado, ya que si se rompe una ampolla, puede iniciarse una infección.
Las quemaduras de tercer grado y las de primero y segundo que afectan una gran zona son más graves. Se envolverá al niño en una sábana limpia, para prevenir la infección, y se sumergirá la zona quemada en agua fría (21°). Si se ha quemado una zona muy extensa, se introducirá en la bañera llena de agua fría, ya que ésta alivia el dolor y previene una mayor destrucción de los tejidos. Si no hay posibilidad de sumergir la parte quemada en agua, se utilizarán compresas húmedas. No se aplicarán sustancias grasientas u otros remedios caseros e inmediatamente se consultará al médico.
Cuando un niño se quema de forma grave, puede sufrir un shock. En este caso, se pondrá al niño estirado en el suelo y se le envolverá en una manta ligera. Se le mantendrán los pies elevados colocando debajo una manta doblada, una almohada u otro objeto. Si el niño se halla consciente y puede tragar, se le dará agua.
Si el niño se quemó con una sustancia química, se lavará inmediatamente la zona con agua comente, utilizando una manguera, ducha o tirándole agua con un cubo u otro recipiente, y entretanto se le irá quitando la ropa de la zona quemada, mientras se continúa tirándole agua.
En este punto se seguirán las instrucciones de primeros cuidados de las otras quemaduras.
Véase también Accidentes; Conmoción; Primeros cuidados; Quemaduras solares
Quemaduras solares
Las quemaduras producidas por el sol son la reacción de la piel ante los rayos naturales ultravioleta del sol o los artificiales producidos por una lámpara de cuarzo. Las quemaduras leves enrojecen la piel, las graves la ulceran y producen fiebre.
Se aplicarán cremas suavizantes a las quemaduras leves. Cuando sean de gravedad se dará aspirina al niño para bajar la fiebre y se le harán ingerir líquidos en abundancia. En el lugar afectado, se le aplicarán compresas de agua fría para aliviar los dolores y si no mejora, se avisará al médico.
El medio más seguro de evitar quemaduras graves es exponerse al sol durante poco tiempo los primeros días (quince minutos tal vez) e ir aumentando progresivamente el tiempo de exposición. Con este sistema, la piel crea defensas que la protegen del sol. Los aceites y broncea- dores también pueden proporcionar una cierta protección.
Los niños con piel blanca y especialmente los pelirrojos son propensos a las quemaduras. Sin embargo, cualquier clase de piel (incluso la más morena) se quemará si permanece expuesta al sol durante cierto tiempo. No se permitirá a un niño que esté demasiado tiempo al sol, particularmente en la playa, ya que los rayos solares reflejados por el agua, intensifican sus efectos. Incluso los días nublados pueden ser peligrosos en la playa.
Quistes
Son bolsas llenas de líquido que se forman en el organismo y que generalmente no tienen abertura. La envoltura es la que produce el material de su contenido.
Los quistes son de todos los tamaños y se pueden formar en cualquier parte del cuerpo. Pueden ser congénitos (el niño nació con ellos) o producidos cuando la abertura de una glándula se obstruye. Algunas veces no se puede determinar cuál es la causa. Muy raramente los quistes son malignos.
Hay quistes que desaparecen espontáneamen262
te, aunque a menudo deben ser tratados por medio de la cirugía. Algunos, como el quiste tirogloso (en el cuello) tienen tendencia a infectarse y otros deben ser extirpados porque interfieren el normal funcionamiento de algún órgano, por ejemplo los quistes de pulmón que dificultan la respiración.
Los quistes superficiales por debajo de la piel son extirpados con facilidad en la misma consulta del médico, pero los más profundos del abdomen o del tórax requieren una operación mayor y la hospitalización.
Raquitismo
Es una afección causada por falta de vitamina D. En ocasiones se debe a que el niño no toma bastantes alimentos ricos en vitamina D. Otras veces se debe a defecto hereditario que impide absorberla. El raquitismo es una afección poco corriente en los países desarrollados.
En la mayoría de los casos se manifiesta antes de los tres años. Los huesos del niño no se calcifican (endurecen) adecuadamente, son blandos y se doblan. El raquitismo en su fase más aguda es causa de que las piernas adquieran forma de arco y de la deformación de los huesos del cráneo, de la columna vertebral y de la pelvis. La malformación de los huesos puede corregirse si no es demasiado grave. Si no se inicia un tratamiento adecuado, los huesos pueden endurecerse en una posición viciosa y deformar permanentemente al niño.
Aunque los alimentos y leche enriquecida con vitamina D y la exposición frecuente a los rayos solares bastan para prevenir el raquitismo, el médico no siempre confiará en estas únicas fuentes y recetará dosis extra de vitamina.
Recetas
Son instrucciones escritas por el médico para prevenir o tratar las enfermedades. La mayoría de las recetas las constituyen medicamentos específicos, pero también incluyen dietas, terapeúticas físicas y ejercicios. En la parte superior de la receta suele haber una “R” que es la inicial latina de la palabra recipe. Los médicos antiguamente escribían en latín el contenido entero de la receta, pero hoy lo hacen en su lengua, exceptuando algunas letras o símbolos.
Se procurará que las recetas sean despachadas por un farmaceútico diplomado y se seguirán exactamente las instrucciones del médico para la administración del medicamento. Se debe tener en cuenta que casi todos los medicamentos son perjudiciales cuando se toman en cantidades superiores a las necesarias.
Otra precaución que se debe recordar es la siguiente: no darle a ningún miembro de la familia medicamentos recetados para otro, aunque los síntomas parezcan similares. El tratamiento y la causa de su otra enfermedad puede ser totalmente diferente.
Recuento sanguíneo
Es la operación de contar las células hemáticas en una determinada muestra de sangre. Dicha muestra se toma generalmente de uno de los dedos de la mano o del lóbulo de la oreja. El recuento se efectúa examinando la muestra al microscopio. La sangre contiene varios tipos de células que tienen cada una de ellas un papel especial en el organismo. Las células más importantes son los glóbulos rojos, los glóbulos blancos y las plaquetas. La sangre normal contiene estas células en una determinada proporción.

Los glóbulos rojos tienen un color brillante debido a un pigmento denominado hemoglobina, que contiene hierro y que además fija el oxígeno en los pulmones y lo transporta a los tejidos del organismo. Los glóbulos blancos atacan y engloban los gérmenes y previenen la infección. Las plaquetas, que son como discos muy pequeños, intervienen, como vimos, en la coagulación de la sangre.
El recuento sanguíneo proporciona al médico una información vital. Así, una cifra de glóbulos rojos baja indica anemia. Una cifra alta de glóbulos blancos indica infección. Un recuento totalmente normal es signo de buena salud.
Véase también Anemia; Coagulación de la sangre; Grupos sanguíneos
Respiración artificial
Cuando se suspende la respiración del niño por cualquier razón, se le practicará la respiración artificial, mientras otra persona va en busca de más ayuda. Si la causa del paro respiratorio es por ahogo en el agua se colocará al paciente estirado en el suelo, boca abajo, ladeándole la cabeza y presionándole la espalda antes de iniciar la respiración artificial, ya que esto hace salir el agua de la faringe y tráquea.
El objeto de la respiración artificial es abrir el paso desde la boca a los pulmones y hacer circular el aire hacia dentro y afuera de los pulmones por medio de la alternancia de la expansión y contracción del tórax.
La respiración artificial boca a boca (llamada también el beso de la muerte), es la forma más efectiva que se puede emplear en los niños. Es la manera de proporcionar una presión positiva para insuflar los pulmones. También es la mejor forma de dar una idea de la presión volumen y ritmo necesario a la persona que la realiza. Cuando se está practicando la respiración artificial a un niño se debe procurar que las insuflaciones sean de poco volumen de aire para que sean sólo un complemento a sus ligeras inspiraciones, que serán una cada tres segundos, aproximadamente.
En el momento de soplar en la boca de un niño (o en la boca y la nariz a la vez) los pulmones se llenan de aire y el tórax se expansiona. Si esto no ocurre es que algo bloquea el paso del aire al pulmón, debiendo asegurarse de nuevo de que no hay nada en la boca y también de que la barbilla se halle dirigida hacia arriba y la mandíbula inferior sea empujada hacia abajo.
Si, después de reasegurarse de la posición de la boca y la barbilla, no se logra todavía que el niño respire, se debe poner enseguida de lado y golpearle vivamente varias veces, entre las paletillas. Esto podrá movilizar algún cuerpo extraño, que quizá no se vio y que se encuentre en la parte alta de la garganta. Cuando se trate de un niño muy pequeño, se podrán vaciar los conductos aéreos sosteniéndolo cabeza abajo, sujeto por los tobillos, o manteniendo con una mano la cabeza inclinada hacia abajo y con la otra gol- péandole con energía entre las paletillas.
Se debe continuar la respiración artificial hasta que el niño inicia su propia respiración o hasta que llegue una ayuda profesional.

Rodillas, actitud defectuosa de las
A veces ocurre que las piernas se incurvan hacia dentro y las rodillas se juntan demasiado. Un niño con este defecto, es posible que incline asimismo los dedos de los pies hacia dentro y los talones hacia afuera. En algunos casos es el resultado del hábito postural de las piernas, siendo más corriente en niños que pesan mucho. La actitud viciosa va empeorando hasta los 5 ó 6 años y luego mejora gradualmente. Muchas veces se corrige por sí sola sin necesidad de tratamiento, hacia los 9 años. Sin embargo, si es un defecto excesivamente visible, el médico le recomendará zapatos ortopédicos o un régimen para reducir el peso del niño.
Otras veces esta actitud defectuosa es el resultado de una lesión o de una enfermedad. Si la causa es una lesión solamente queda afectada una rodilla. En estos casos la posición no se corrige con el tiempo y es necesario recurrir a medios ortopédicos o a la cirugía.
Véase también Obesidad; Piernas curvas; Pies, cuidados de los; Pies planos
Roséola epidémica
Se caracteriza por una erupción en la piel, acompañada de fiebre. Los médicos creen que es causada por un virus. Por lo general afecta a los niños desde los seis meses a los tres años. Es la enfermedad más corriente (produciendo fiebre y erupción en la piel) en los niños menores de dos años.
Normalmente empieza con 39° ó 40° C de temperatura. Al cabo de tres o cuatro días ésta desciende repentinamente hasta alcanzar la normalidad o incluso situarse por debajo de ella. Entonces, en el pecho, en el abdomen y en el cuello aparece una erupción de manchas rosadas pequeñas y planas. Es muy raro que se extienda a la cara, brazos y piernas. Dura un día o dos, pero a veces desaparece a las pocas horas. La enfermedad generalmente inmuniza.
Se debe avisar al médico si se observan estos síntomas. Probablemente recetará aspirinas para rebajar la fiebre y líquidos para evitar la deshi- dratación. No es necesario aislarlo.
Rubéola
Se llama también el sarampión alemán o de los tres días y es una enfermedad contagiosa causada por un virus. El niño puede ser vacunado contra ella después del año de edad.
La rubéola se da en niños comprendidos entre los cinco y los quince años y aparece comúnmente al final del invierno y en primavera.
Los primeros síntomas son fiebre moderada, dolor de garganta, dolor de cabeza, endurecimiento e hinchazón de los ganglios del cuello y de detrás de las orejas y posible erupción de color rosado, comenzando a aparecer entre los 14 y 21 días después del contagio.
La erupción se inicia en la cara y se extiende al resto del cuerpo, durando dos o tres días. Al principio, las manchas están separadas y progresivamente se van uniendo. En los niños muy pequeños, la erupción puede ser el primer síntoma.

La mayoría de los casos son tan leves que no es preciso guardar cama. Hay peligro de contagio desde siete días antes de que aparezca la erupción, hasta cinco días después. Una vez padecida la enfermedad, queda inmunizado. Es aconsejable que las niñas sufran la enfermedad durante la infancia, ya que si cuando están embarazadas se contagian de ella durante los tres primeros meses del embarazo, el niño puede nacer con cataratas, sordera, retraso mental y otros defectos. Si una embarazada estuvo expuesta a un caso de rubéola, debe ir al médico lo antes posible.
Véase también Enfermedades contagiosas; Inmunización; Virus